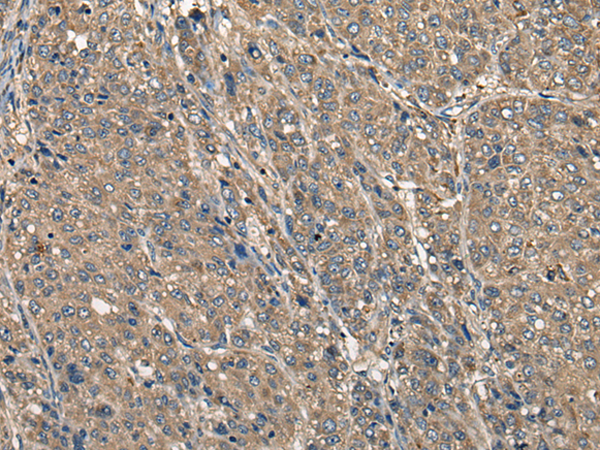

中文名稱:兔抗CD5多克隆抗體
英文名稱: Anti-CD5 rabbit polyclonal antibody
別 名: CD5 molecule; T1; LEU1
相關(guān)類別: 一抗
抗 原: CD5
儲(chǔ) 存: 冷凍(-20℃)
宿 主 : Rabbit
反應(yīng)種屬: Human, Mouse, Rat
標(biāo) 記 物: Unconjugate
克隆類型: rabbit polyclonal
技術(shù)規(guī)格
|
Background: |
CD5 (also designated Lyt-1) has been identified as a transmembrane glycoprotein that is expressed on 70% of normal peripheral blood lymphocytes and on virtually all T lymphocytes in thymus and peripheral blood. Activation of T cells through the T cell receptor (TCR) results in tyrosine phosphorylation of CD5, and the absence of CD5 renders T cells hyper-responsive to TCR-mediated activation. CD5 associates with the TCR/ CD3-ζ chain and with the Src family kinase Lck p56. In vitro studies have shown a 10- to 15-fold increase in the kinase activity of Lck bound to CD5. The B cell antigen, CD72, serves as a receptor for CD5. The consequence of CD5 binding to its cognate receptor is still in question and likely plays a role in thymic selection. May act as a receptor in regulating T-cell proliferation. |
|
Applications: |
ELISA, IHC |
|
Name of antibody: |
CD5 |
|
Immunogen: |
Synthetic peptide of human CD5 |
|
Full name: |
CD5 molecule |
|
Synonyms: |
T1; LEU1 |
|
SwissProt: |
P06127 |
|
ELISA Recommended dilution: |
5000-10000 |
|
IHC positive control: |
Human liver cancer |
|
IHC Recommend dilution: |
30-150 |
購物車
幫助
021-54845833/15800441009
